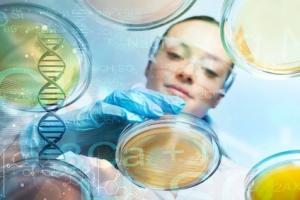
Vaincre la leucémie en ciblant ses cellules souches quiescentes (Visuel Fotolia 123592855) Vaincre la leucémie en ciblant ses cellules souches quiescentes (Visuel Fotolia 123592855)

Vous recherchez une actualité ou un dossier
Recherche (liste)
Mode d'affichage :
-
LEUCÉMIE myéloïde aiguë : Le traitement du cancer du sein qui surmonte la résistance
Actualité publiée le 05/01/2026LEUCÉMIE : Un test sanguin de détection du risque ?
Actualité publiée le 06/11/2025
-
VIRUS T-LYMPHOTROPIQUE HUMAIN 1 (HTLV-1) : Perspective d’un premier traitement
Actualité publiée le 09/09/2025Un champignon contre le CANCER
Actualité publiée le 03/08/2025
-
LEUCÉMIE myéloïde : Un cocktail qui reprogramme les cellules cancéreuses
Actualité publiée le 25/07/2025LEUCÉMIE : S’y attaquer par les cellules souches
Actualité publiée le 16/10/2024
-
ADRÉNOLEUCODYSTROPHIE CÉRÉBRALE : Le grand espoir de la thérapie génique
Actualité publiée le 14/10/2024LEUCÉMIE myéloïde : L’espoir d’un médicament expérimental contre le diabète
Actualité publiée le 20/09/2023
-
LEUCÉMIE INFANTILE : Ces infections maternelles qui peuvent la favoriser
Actualité publiée le 03/05/2023TRISOMIE 21 : L’édition du génome révèle le gène qui cause la leucémie
Actualité publiée le 25/04/2023
-
LEUCÉMIE : L’édition de gènes pour des cellules T plus efficaces et universelles
Actualité publiée le 18/01/2023DIABÈTE : L’anticancéreux qui pourrait faire mieux que la metformine
Actualité publiée le 17/11/2022
-
LEUCÉMIE : Vers une nouvelle forme de chimio ?
Actualité publiée le 07/10/2022LEUCÉMIE : Le gène qui manque aux cellules du sang
Actualité publiée le 09/05/2022
-
COVID-19 : Le cas le plus long était asymptomatique
Actualité publiée le 08/10/2021LEUCÉMIE myéloïde : Un nouvel inhibiteur de l'autophagie pour un traitement plus efficace
Actualité publiée le 01/10/2021
-
LEUCÉMIE myéloïde aiguë : CRISPR identifie une nouvelle cible prometteuse
Actualité publiée le 14/09/2021LEUCÉMIE : 2 mutations qui influent sur la létalité synthétique
Actualité publiée le 09/09/2021
-
LEUCÉMIE : Booster les cellules tueuses naturelles, c'est possible
Actualité publiée le 13/06/2020GLIOME : Priver de cholestérol les cellules cancéreuses
Actualité publiée le 03/06/2019
-
CANCER : Il détourne le microbiome et pille le glucose
Actualité publiée le 02/11/2018LEUCÉMIE INFANTILE : Une conséquence extrême de l’hypothèse de l’hygiène ?
Actualité publiée le 23/05/2018
-
CANCER : Un traitement de la leucémie efficace contre les tumeurs solides
Actualité publiée le 21/02/2018OBÉSITÉ : Un effet pernicieux sur le système sanguin du corps
Actualité publiée le 17/01/2018
-
CANCER du SANG : La mélatonine stimule la réponse immunitaire contre la tumeur
Actualité publiée le 11/09/2017LEUCÉMIE : Des injections de vitamine C pour freiner la maladie
Actualité publiée le 23/08/2017
-
LEUCÉMIE : Le sang a besoin de sa dose de vitamine A
Actualité publiée le 17/05/2017LEUCÉMIE : Et si les virus T-lymphotropes existaient depuis 40 millions d'années
Actualité publiée le 06/03/2017
-
LEUCÉMIE MYÉLOÏDE CHRONIQUE: Le traitement qui tue 90% des cellules souches leucémiques
Actualité publiée le 15/09/2016